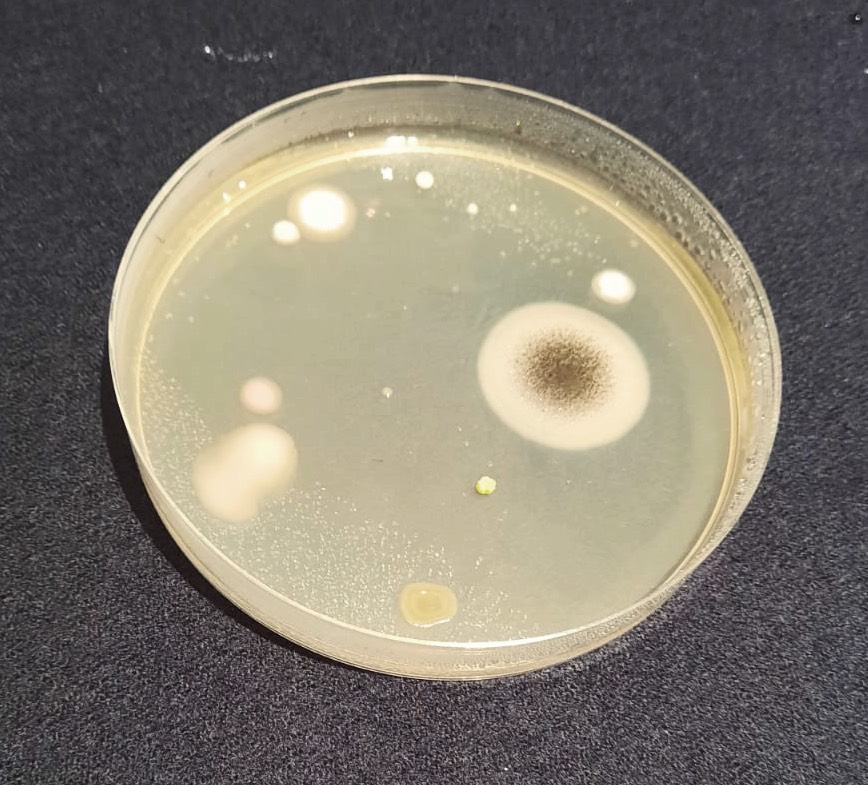

Ha avuto inizio giovedì 10 novembre la quindicesima edizione del Cagliari FestivalScienza che si svolge in diversi punti della città, dalle sale interne agli spazi esterni dell’Exmà ma anche nell’Aula Magna del Rettorato e la Sala Conferenze della Fondazione di Sardegna. Sono coinvolte anche la Biblioteca Universitaria, la Biblioteca Emilio Lussu al Parco di Monte Claro, il Liceo Artistico Foiso Fois, le strutture scolastiche e sportive del quartiere Sant’Elia, imusei di geologia e paleontologia, l’herbarium, quello di zoologia, chimica, antropologia e etnografia. Non mancano i contributi del Sardinia Radio Telescope, l’Osservatorio Astronomico e ancora la necropoli e il parco del Colle di Bonaria e il Parco Naturale Regionale di Molentargius. Il festival interessa Cagliari fino al 13, ma poi ci sono degli speciali a Nuoro il 15 e 16, a Oristano il 17, Siniscola 18 e 19, la zona del Sarcidano-Trexenta nei giorni dal 21 al 23 e infine Iglesias dal 24 al 26.
LEGGI ANCHE: Cagliari FestivalScienza, l’affascinante viaggio di Marco Ciardi tra le pseudoscienze dall’alchimia ad Atlantide
Un programma ricchissimo e ampio (QUI IL LINK AL CALENDARIO), curato dall’associazione Scienza Società Scienza, che sta già entusiasmando i visitatori e che connette realtà liminari creando un tessuto fitto di iniziative e collaborazioni.
Visti per voi, iniziamo con un’alga
Giovedì mattina gli spazi dell’Exmà erano popolati da allievi e allieve di diversi ordini e gradi scolastici, sia come partecipanti ai laboratori che come protagonisti, questi ultimi hanno dato informazioni, spiegazioni e guidato i visitatori. Molti docenti delle scuole medie e superiori hanno lavorato in grande anticipo per preparare i propri allievi in attività di divulgazione come nel caso della prodigiosa spirulina, un’alga dalle molte proprietà. Dalla coltivazione al suo trattamento per essere usata in varie preparazioni, anche gastronomiche, i giovani dell’Istituto Comprensivo n°2 di Quartu Sant’Elena ci hanno guidato in un percorso articolato in cinque tappe.
Geometrie perfette
Gli spazi espositivi ci presentano una varietà di soggetti, come quello delle Tassellazioni e degli oggetti matematici che diventano realtà. Come i solidi platonici e i poliedri stellati che da sempre esercitano un grande fascino e hanno trovato larga applicazione anche in elementi architettonici o che ritroviamo nel mondo dei cristalli.


Dalla geometria alle muffe, batteri e virus. Ad accoglierci una fila di microscopi in cui poter osservare come sono fatti, il piccolo mondo che sfugge al nostro sguardo. E naturalmente non mancano, nemmeno qui, giovani ed esperti pronti a soddisfare le nostre curiosità.

Disabilità visiva e matematica e rompicapo scientifici
La matematica e la cecità è il tema di un laboratorio in cui sono state illustrate quali metodologie e strumenti consentono ai non vedenti di studiare le discipline scientifiche. Per chi ama le sfide di coding e i quiz di astrofisica, CodyMaze Astrofisico è un labirinto di cubi interattivi, dotati di QR code. Una scacchiera 5×5 in cui spostarsi da un cubo all’altro tentando di risolvere i rompicapo scientifici.

La serie più affascinante della matematica e la sezione che è in ogni cosa

Non ci siamo fatti mancare il fascino di Fibonacci e della sezione aurea nelle geometrie disegnate dalla natura nel mondo vegetale. Si vedono chiaramente le regolarità matematiche che la natura segue nella sua organizzazione. Osservare e disegnare e riprodurre questi modelli è stata una delle attività proposte ai giovani visitatori le cui manine hanno disegnato ispirate dall’osservazione delle ricorrenze formali.
Il suono che dà forma
Il laboratorio di 10LAB e Sardegna Ricerche propone curiosità tra scienza, tecnologia e esperimenti che mostrano come unendo i saperi si possa non solo comprendere meglio il mondo ma anche innovare per un futuro migliore. Molto interessante e coinvolgente la magia del suono che con le sue forme d’onda può letteralmente geometrizzare la materia. Ce ne dà un esempio l’esperimento di cimatica in cui sfregando l’archetto di un violino sul bordo di una piastra di metallo su cui era stata posta della semola di grano, la vibrazione conseguente o inerente al suono prodotto ha letteralmente riordinato i granelli di semola dandogli forme ben precise.

Quando non sappiamo spiegare un fenomeno lo chiamiamo magia, quando ne comprendiamo le leggi che lo governano la chiamiamo scienza e forse è proprio questo il bello dell’eterna scoperta.
Il Festival Scienza è altamente raccomandato a tutti. Per chi ama la scienza è una occasione per entrare in contatto con le novità, per chi ha un approccio più umanistico, è senz’altro una opportunità per essere ispirati dal pullulare di scoperte e dal meraviglioso mondo perfetto delle leggi che governano le nostre vite.














